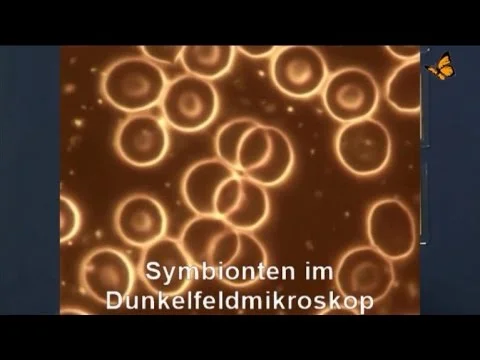

#153 - Erklärwerk
Müssten wir nicht alle wissen, wie Licht schmeckt? Und warum werden zahlreiche Raucher gebraucht, wenn mal wieder eine Riesenspinne in der Bananenkiste mitgereist ist? Der Letzte Podcast klärt auf...
Aktuelle Podcasts von Die Letzte Filmkritik
Links & Videos zum Podcast
Lichtnahrung:
- Wikipedia über Lichtnahrung
 
Filmecke:
- Movie Deathmatch: The Predator vs. MI:6
 - Die Letzte Filmkritik: Baby Driver
 
Games:
Alle weiteren Themen:
- Das Letzte Subreddit - Einfach anschreiben, wir schalten euch dann für unsere Community frei!
 - Das Letzte Wiki über Das Letzte Wiki 2.0
 - Bananenkiste sorgt für Rauchoffensive
 - Der Letzte Podcast mit ältester Spinne der Welt
 - Geld weggeflogen: Der größte Tollpatsch seit Naddel
 - Warum nur kacken, wenn man dabei auch duschen kann? (KEIN Affiliate-Programm)
 - Finderlohn gibt's nur fürs Museum, aber nicht für den Finder
 - Kleiner Pornogucker hat in der Schule das Wort "Gratis" noch nicht dran gehabt